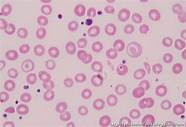
铁之缘片效果怎么样与之缘

创业资讯门户网站
用药说明
铁之元铁之缘片效果怎么样片:3片,一日3次,维生素C: 2片,一日3次。
这个铁缘片里面的主要成分就是这个铁剂,这个铁剂是合成血红蛋白最传统的中药材料,而这个血红蛋白是红细胞的主要成分,所以补铁可以起到治疗贫血的作用,而这个维生素在这里的主要作用就是促进铁剂的吸收。
用药周期
三月
反作用
需要注意的事项
吃药的时候多注意休息,然后多吃点西红柿和橘子,然后做饭的时候尽量用这个铁锅做饭,加强营养。
药物效应
这两种药的治疗效果还是不错的。吃了他们一个月后去医院做了血常规检查,贫血好了很多,然后三个月后就完全纠正了。
相关经验
孕妇用硫酸亚铁缓释片治疗缺铁性贫血效果好吗?
生宁片对贫血的效果好吗?
铁之元片和维生素C片合用对贫血有较好的疗效。
贫血儿童应使用铁边缘片。
自1978年开工以来,历经44年,三北工程已经完成了前五期的建设任务。
“三北工程”是指在我国三北地区(西北、华北、东北)建设的大型人工林业生态工程。该项目共分八期,占中国国土总面积的45%,被誉为“绿色长城”。
2011年至2020年为“三北五期工程”建设期。2020年,国家林草局三北防护林工程建设局会同相关专业机构对三北工程五期工程建设进行了总结评估,形成《三北防护林体系建设五期工程评估报告》。
第三个五年计划取得了哪些生态、经济和社会效益?与前四个项目相比有哪些变化?
“在生态效益方面,三北地区生态环境质量呈现稳中向好的态势,自然生态系统恶化趋势基本得到遏制,沙尘暴危害得到有效缓解,水土流失得到有效控制,护农促牧屏障日益完备。”国家林草局三北局副局长张亮说。
到2020年底,第五期工程累计造林面积达到万公顷,40多年累计造林面积达到万公顷。项目区森林覆盖率由第四期期末的%提高到第五期期末的%,黄土高原、毛乌素沙地、科尔沁沙地、呼伦贝尔沙地等重点地区生态治理进程明显加快。
张亮说,在经济效益上,三北工程坚持生态治理和民生改善协调推进,特色林果产业和林下经济初具规模。绿色富民产业在帮助群众脱贫方面成效显著。
据测算,五期工程完成的造林总生态效益每年可达1亿元。到项目第五期结束时,已帮助1500万农民脱贫,贡献率为27%。三北地区全年森林旅游接待游客3.85亿人次,旅游直接收入达480亿元。
“在社会效益上,人居环境得到极大改善,生态文化日益丰富,生态文明意识普遍提高。”张亮指出,通过道路绿化、城乡美化和亮化,可以改善生活环境。根据第九次全国森林资源清查结果,三北工程区人均森林面积已达0.26公顷。
“与前四个项目相比,第五个项目在建设理念、内容和布局上都实现了创新和突破。”张亮说。
张亮说,五期工程的建设理念更加注重自然恢复,封山(沙)造林占工程任务的%,是四期工程的2.8倍。同时,建设内容更加注重数量和质量并重,遵循防护林建设规律,创造性地将退化森林恢复纳入建设。在项目的第五阶段,总共恢复了10,000公顷退化的森林。
“工程建设重点逐步向西部地区倾斜,合理规划布局东北华北平原农业区、风沙区、黄土高原丘陵沟壑区和西北沙漠区四个建设区域。”张亮指出,第五期工程按照突出重点、规模经营、建设防护林基地的战略,大力推进重点工程建设,1500万亩防护林基地、2个大型林场、33个黄土高原林业综合治理示范县、30个精准治沙县和退化森林恢复工程相继启动,取得了明显成效
“目前,我们正在开展退化林草调查,旨在全面掌握项目区退化林草数据,建立三北工程退化林草数据库,为实施退化林草精准恢复提供重要依据。”张亮说。
今年5月,国家林草局发布《关于全面推进三北工程科学绿化的实施意见》,对推进三北工程科学绿化深入发展作出了政策和制度安排。
张亮说,“前几天,我们正式启动了三北工程科学绿化20个试点县建设,并下发了《三北工程县域科学绿化技术指南(试行)》,将进一步探索水、土、气、气等生态要素协调、科学发展国土绿化的新路子。”

2021年至2030年为三北第六期工程建设期。张亮表示,三北六期工程将重点建设一批有特色、有规模、高质量的示范工程,形成林草区域系统化管理、规模化经营、科学绿化、精准提质的三北工程高质量发展模式。
SourcePh
style='display:none '